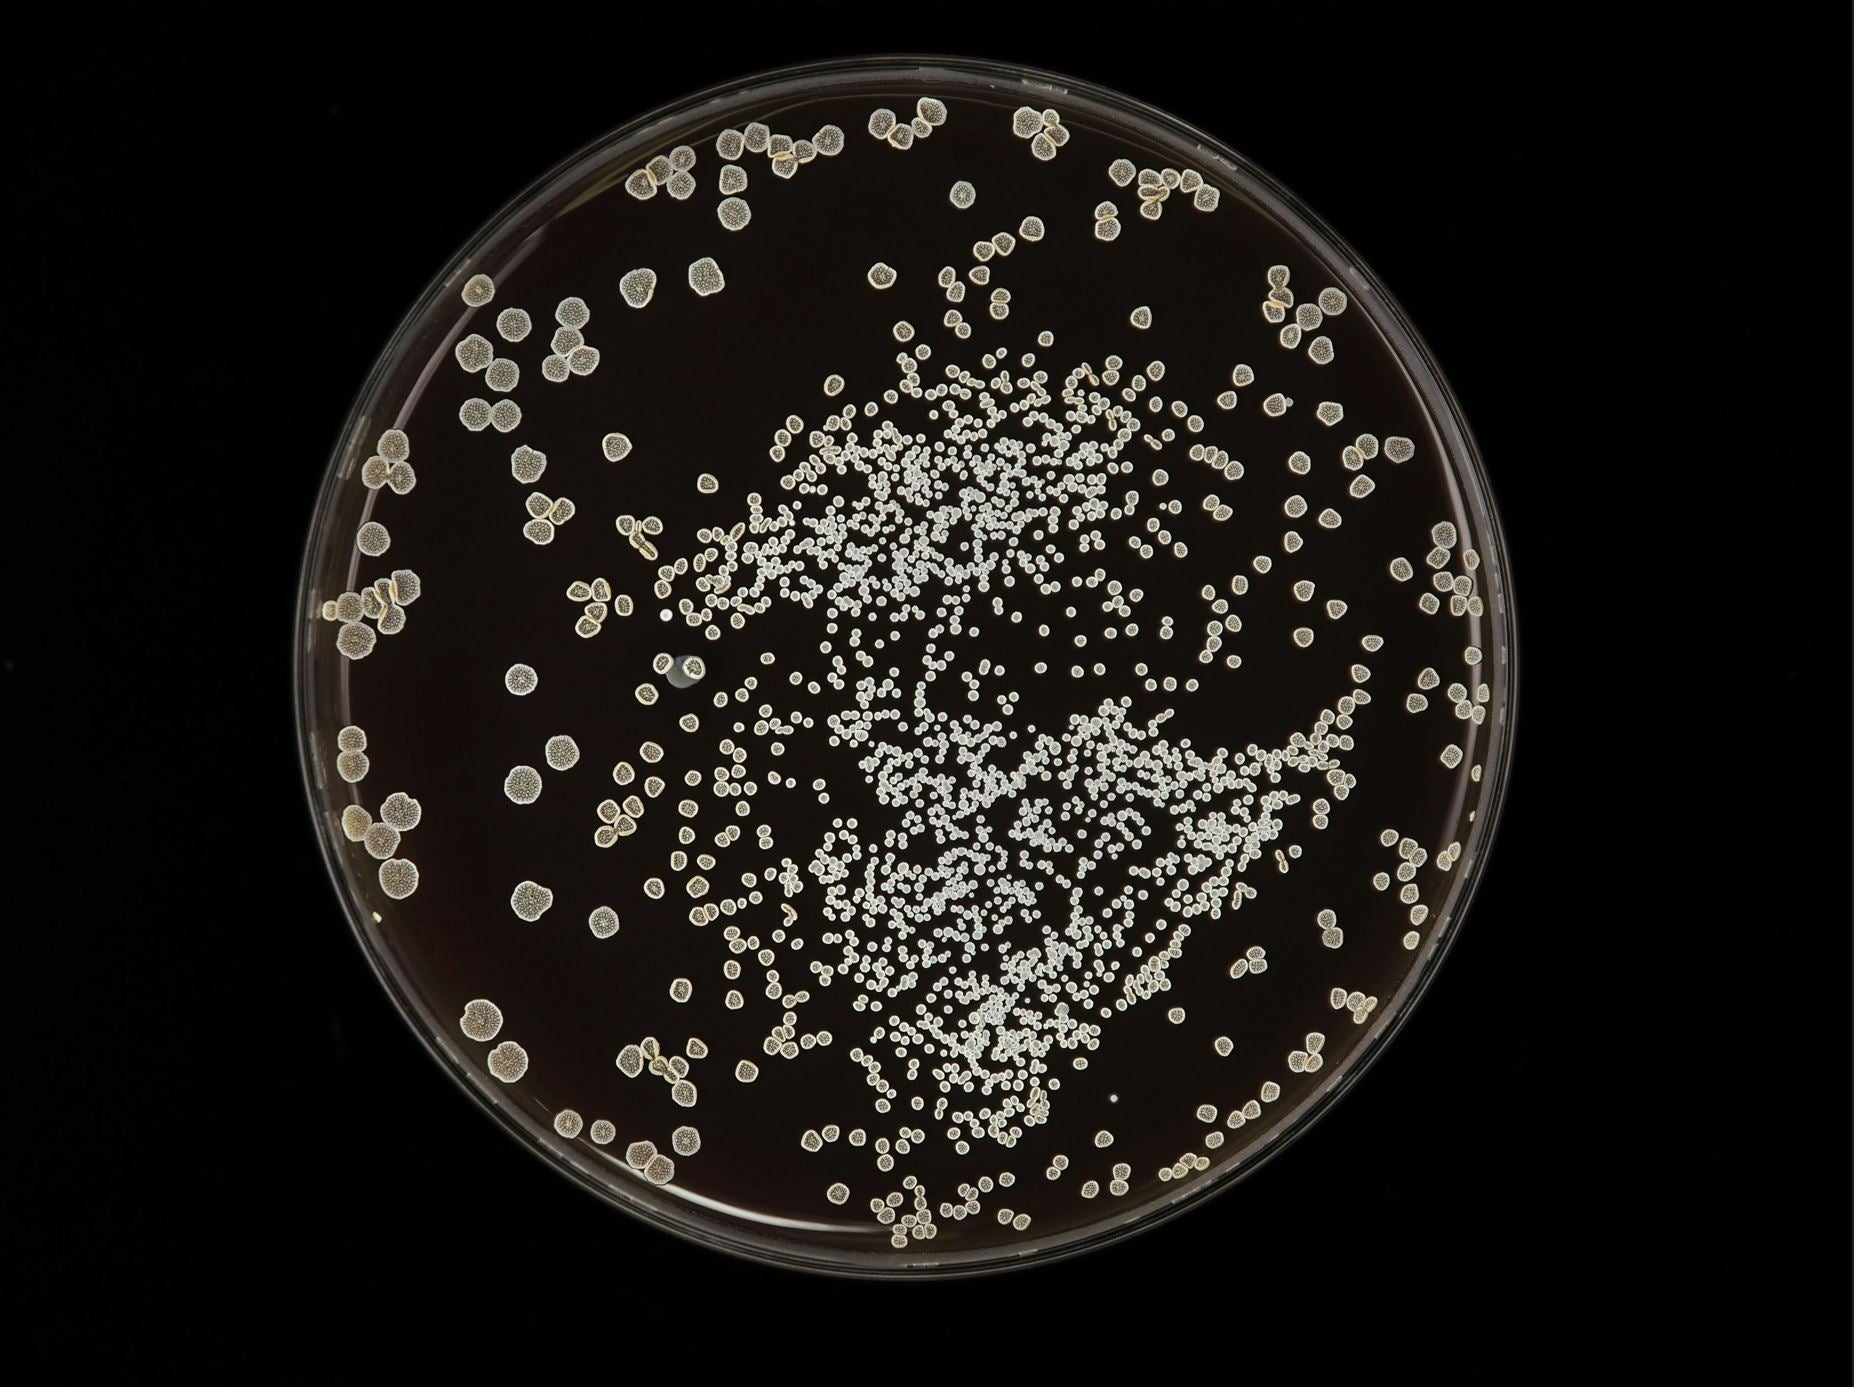
THE SCIENCE OF FRAGRANCE DISPERSION

SafeAir Does Not Have the Dangers of Your Typical Fragrance Diffuser
All ultrasonic evaporative and heat evaporative diffusers emit bacteria into the air unless cleaned daily. Cleaning rarely takes place, and this issue is not widely publicized. The Arome D’Art SafeAir system is the only technology that solves this problem.
Facts About Evaporative Diffuser Cleanliness:
1. “There are two types of essential evaporative oil diffusers: ultrasonic diffusers and atomizing diffusers.
a. Ultrasonic diffusers have a water reservoir and an ultrasonic plate, which are exposed to water and essential oils.
b. Atomizing diffusers may have a glass nebulizer or plastic tubing which is directly exposed to oils without water.”
2. You should clean your diffuser each time you use it. Use a microfiber cloth or Q-tip to wipe away any excess oil or water and give the equipment a more thorough cleaning by wiping everything down with rubbing alcohol. Cleaning gets rid of standing water, where mold and mildew can grow. You must clean your diffuser after each use to also prevent bacteria build up and to prevent scents from mixing the next time you use it.
a. Diffusers have various components that may degrade prematurely if not maintained properly.
b. Exposure to tap water may cause mineral buildup; exposure to essential oils left on surfaces may cause gummy residue buildup; and remaining essential oils may blend with the next oils, resulting in changes in aroma and constituents.
c. Ideally, you’d give your diffuser a quick rinse, then dry it with a soft cloth after every use. This is especially important if you’re switching oils. You don’t want water to remain in the reservoir over extended periods of time, as this can cause mold and mildew to grow in the stagnant water and oily residues to form on the surface. Deep cleaning removes dust and residue buildup that affect how well your diffuser works.
d. After all the cleaning, you must reassemble the diffuser, which can take time. Hardly anyone bothers with this cumbersome task!
3. The main issue is that people do not clean their diffuser. The result is bacteria in the air from mold that grows in the diffuser.